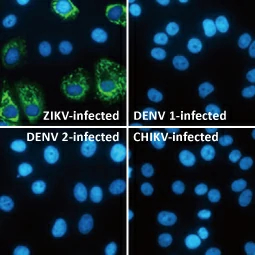
Zika Virus Envelope protein antibody (GTX133314) Zika Virus Envelope protein antibody (GTX133314)

![]() |
|
病毒是小的感染因子,存在于“有生命的”和“无生命的”实体之间的灰色区域,与大多数细菌、真菌或寄生虫相反,病毒完全依赖宿主细胞进行复制,通过病毒基因组编码因子的作用劫持了细胞的生化机制。病毒颗粒的基本结构包括蛋白质外壳或衣壳内的DNA或RNA基因组,对于某些病毒,该衣壳被包封在通常来自宿主细胞膜的脂质包膜中,病毒附着于宿主细胞上的特定受体会导致内在化,并经常引发新一轮的病毒复制。 |
|
有200多种可以感染人类的病毒,其中不包括许多针对人类使用的动植物而影响人类的病毒,这些病毒病原体包括流感病毒、登革热病毒、日本脑炎病毒(JEV)、肝炎病毒(例如HCV和HBV)、肠病毒(EV71、EV68和柯萨奇病毒)和寨卡病毒。 GeneTex提供广泛的抗体试剂目录,这些目录可以帮助您研究上述病毒和其他病毒。 |
| GeneTex 用于病毒传染病研究的综合产品和文献目录 | |||||
|
|
|||||
|
|
|
|
||||||||||||
|
|
|
|
||||||||||||
|
|
|
|
||||||||||||
|
|
|
|
||||||||||||
|
|||
| 热门研究产品 | |||||
|
|
|||||
|
|
|
|
||||||||||||||||
|
|
|
|
||||||||||||||||


















![ASFV p54 antibody [HL1289] (GTX636703) ASFV p54 antibody [HL1289] (GTX636703)](/upload/media/research/Infectious-Diseases/homepage/data/dataImg_250x250_01.webp)
![ASFV p54 antibody [HL1289] (GTX636703) ASFV p54 antibody [HL1289] (GTX636703)](/upload/media/research/Infectious-Diseases/homepage/data/dataImg_250x250_02.webp)
![Chikungunya Virus nsP2 antibody [HL1488] (GTX636962) Chikungunya Virus nsP2 antibody [HL1488] (GTX636962)](/upload/media/research/Infectious-Diseases/homepage/data/dataImg_250x250_03.webp)
![Respiratory Syncytial Virus Nucleoprotein antibody [HL1248] (GTX636650) Respiratory Syncytial Virus Nucleoprotein antibody [HL1248] (GTX636650)](/upload/media/research/Infectious-Diseases/homepage/data/dataImg_250x250_07.webp)
![Influenza A Virus Nucleoprotein antibody [HL1103] (GTX636318) Influenza A Virus Nucleoprotein antibody [HL1103] (GTX636318)](/upload/media/research/Infectious-Diseases/homepage/data/dataImg_250x250_05.webp)

![Respiratory Syncytial Virus Nucleoprotein antibody [HL1248] (GTX636650) Respiratory Syncytial Virus Nucleoprotein antibody [HL1248] (GTX636650)](/upload/media/research/Infectious-Diseases/homepage/data/dataImg_250x250_08.webp)
![SARS-CoV-2 (COVID-19) Spike S1 antibody [HL6] (GTX635654) SARS-CoV-2 (COVID-19) Spike S1 antibody [HL6] (GTX635654)](/upload/media/research/Infectious-Diseases/homepage/data/dataImg_250x250_09.webp)
![SARS-CoV-2 (COVID-19) Spike S1 antibody [HL6] (GTX635654) SARS-CoV-2 (COVID-19) Spike S1 antibody [HL6] (GTX635654)](/upload/media/research/Infectious-Diseases/homepage/data/dataImg_250x250_10.webp)
![Venezuelan Equine Encephalitis Virus nsP2 antibody [HL1919] (GTX637668) Venezuelan Equine Encephalitis Virus nsP2 antibody [HL1919] (GTX637668)](/upload/media/research/Infectious-Diseases/homepage/data/dataImg_250x250_11.webp)